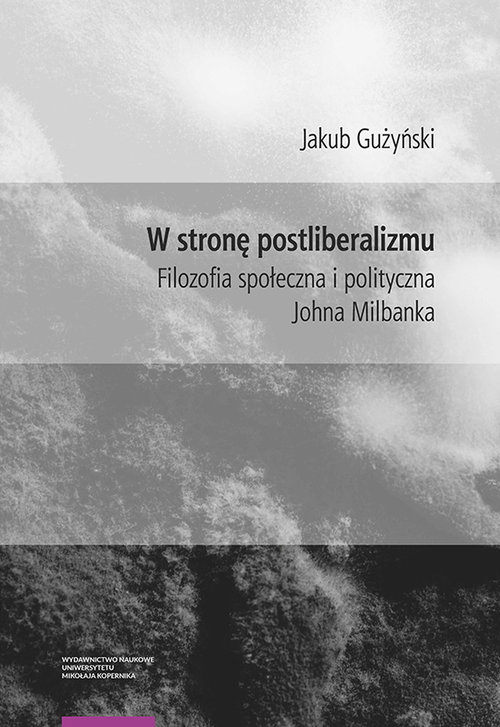

Książki
Książki
- Albumy
- Atlasy. Mapy. Przewodniki
- Biografie, wspomnienia
- Ekonomia i biznes
- Encyklopedie i słowniki
- Ezoteryka
- Fantastyka
- Historia
- Hobby
- Informatyka
- Kalendarze
- Kryminał i sensacja
- Książki dla dzieci
- Książki dla młodzieży
- Książki kulinarne
- Książki obcojęzyczne
- Książki okolicznościowe
- Książki z dużą czcionką
- Literatura
- Literatura faktu
- Literatura kobieca
- Nauka języków obcych
- Nauki humanistyczne
- Nauki przyrodnicze i ścisłe
- Oferta Nagrodowa
- Podręczniki akademickie
- Podręczniki szkolne
- Pomoce edukacyjne
- Poradniki
- Prawo i administracja
- Religia i teologia
- Sport
- Zdrowie i medycyna
Papiernia
Papiernia
- Artykuły biurowe
- Artykuły piśmiennicze
- Artykuły szkolne
- Druki i formularze
- Karnety i pocztówki
- Kosze
- Kreatywne
- Na imprezę
- Makijaż
- Naklejki
- Notatniki
- Oferta Świąteczna
- Opakowania
- Pamiętniki
- Papeterie
- Pomoce naukowe
- Przybory rysunkowe
- Serwetki
- Szkicowniki
- Tekstylia
- Torby, plecaki
- Zakładki do książek
- Zakładki indeksujące
- Zeszyty
Zabawki
Zabawki
- Bal przebierańców
- Dla chłopców
- Dla dzieci
- Dla najmłodszych
- Dla niemowląt
- Do kąpieli
- Edukacyjne
- Elektronika dla dzieci
- Figurki
- Gry
- Impulsowe
- Interaktywne
- Karty
- Klocki
- Lalki
- Logiczne
- Maskotki i pluszaki
- Modelarstwo
- Muzyczne
- Pojazdy
- Roboty
- Sensoryczne
- Sport i rekreacja
- Sztuczki magiczne
- Świecące w ciemności
- Tablice, znikopisy
- Tatuaże i makijaż
- Zabawa w dom
- Zabawki drewniane
- Zabawki kreatywne
- Zręcznościowe zabawki
Gry
Gry
Puzzle
Puzzle
Multimedia
Multimedia
Komiksy
Komiksy
Różności
Różności
Skarpetki
LEGO
LEGO
- Animal Crossing
- Architecture
- Art
- Avatar
- City
- Classic
- Creator
- Disney
- Disney Princess
- Dots
- Dreamzzz
- Duplo
- Flowers
- Friends
- Functions
- Gabby's Dollhouse
- Harry Potter
- Icons
- Ideas
- Indiana Jones
- Juniors
- Jurassic World
- Marvel
- Minecraft
- Ninjago
- Opakowania zbiorcze
- Speed Champions
- Star Wars
- Super heroes
- Super Mario
- Technic
- Inne LEGO
- LEGO Akcesoria
Promocje